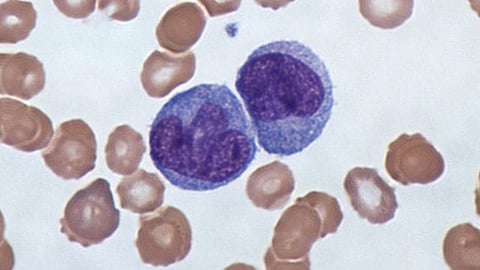
Monocytes are short-lived circulating immune cells that are a precursor to macrophages, immune cells able to engulf and destroy viruses, bacteria and other cells foreign to the host.

To develop treatments that may one day entirely rid the body of HIV infection, scientists have long sought to identify all of the places that the virus can hide its genetic code. Now, in a study using blood samples from men and women with HIV on long-term suppressive therapy, a team led by Johns Hopkins Medicine scientists reports new evidence that one such stable reservoir of HIV genomes can be found in circulating white blood cells called monocytes.
Monocytes are short-lived circulating immune cells that are a precursor to macrophages, immune cells able to engulf and destroy viruses, bacteria and other cells foreign to the host.
In the current research, published March 27 in Nature Microbiology, the scientists found evidence that blood samples from people with HIV undergoing long term, standard antiretroviral therapy contained monocytes that harbor stable HIV DNA capable of infecting neighboring cells.
The scientists say the findings may provide a new direction for efforts to improve therapies and eventually cure HIV, which affects more than 34 million people worldwide, according to the World Health Organization. Current antiretroviral drugs can successfully suppress HIV to nearly undetectable levels, but have not resulted in total eradication of the virus.
“We don’t know how critical these monocytes and macrophages are to eradication of HIV, but our results suggest we should continue research efforts to understand their role in this disease,” says Janice Clements, Ph.D., professor of molecular and comparative pathobiology at the Johns Hopkins University School of Medicine.
Scientists have long known that HIV stashes its genome most often in a type of immune cell called a CD4+ T-cell. These hiding places are known as reservoirs.
“To eradicate HIV, the goal is to find biomarkers for cells that harbor the HIV genome and eliminate those cells,” says Rebecca Veenhuis, Ph.D., assistant professor of molecular and comparative pathobiology at the Johns Hopkins University School of Medicine.
To further study the role of monocytes and macrophages in circulating blood as HIV reservoirs, the Johns Hopkins-led team of scientists obtained blood samples between 2018 and 2022 from 10 men with HIV, all of them taking long-term, standard antiretroviral medications.
The researchers extracted blood cells from the samples and grew the cells in the laboratory. Typically, monocytes transform very quickly — within about three days — into macrophages, producing monocyte-derived macrophages.
All 10 men had detectable HIV DNA in their monocytes-turned-macrophages, but at levels 10 times lower than those found in the men’s CD4+ T cells, the well-established HIV reservoir.
For the next phase of the research, to determine if HIV genomes were present in monocytes prior to macrophage differentiation, the team used an experimental assay to detect intact HIV genomes in monocytes. The assay was based on one that fellow Johns Hopkins scientist Robert Siliciano, M.D., Ph.D., developed in 2019 to detect the HIV genome in CD4+ T cells.
The scientists, including research associate Celina Abreu, Ph.D., used the assay on blood samples taken from another group of 30 people (eight men from the first group and 22 female participants) with HIV, also treated with standard antiretroviral therapy. The researchers found HIV DNA in the CD4+ T cells and in monocytes of all 30 participants.
The scientists were also able to isolate HIV produced by infected monocytes from half of the research participants. The virus extracted from these cells was able to infect CD4+ T cells.
Three of the participants had their blood examined several times over the four-year study period, and each time, the scientists found HIV DNA and infectious virus produced by their monocyte-derived macrophages. “These results suggest that monocytes may be a stable reservoir of HIV,” says Clements. (PB/Newswise)